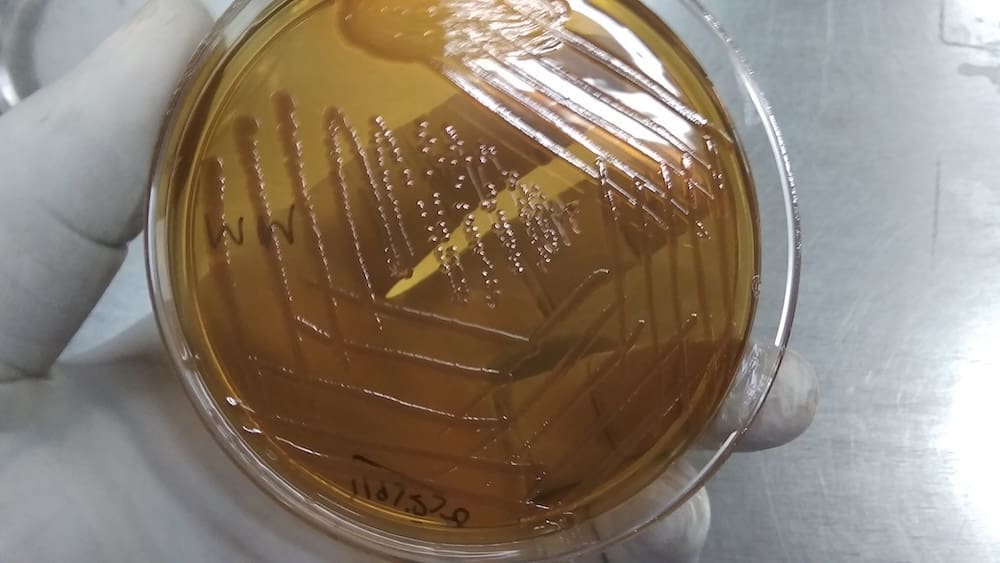

Morgan pure
Substance Background
Morgan pure is Paterson’s later, more specific Morgan bowel nosode, prepared from a single, stable sub-type selected out of Bach’s original composite “Morgan Bach” group of non-lactose-fermenting bowel bacilli. In Bach’s work, the Morgan group was a broad collection of related coliform organisms repeatedly isolated from the stools of patients with chronic skin, liver, bowel, and venous conditions; from this composite he prepared the original Morgan Bach nosode. [Bach], [Paterson]
Paterson’s long-term subculture studies then revealed that this broad Morgan group could be subdivided into more biochemically stable strains. One of these maintained a consistent pattern of reactions through repeated cultures, without developing additional fermentations such as dulcitol; this he named Morgan pure. It is therefore not the same as Morgan Bach: Morgan Bach is the original broad composite nosode representing the whole Morgan group as Bach defined it; Morgan pure is a narrower, more sharply defined sub-nosode that Paterson separated out from within that larger group. A third related nosode, Morgan Gaertner, was prepared from Morgan strains that developed extra reactions (notably dulcitol fermentation) and showed a closer relationship to the Gaertner–Gaertn. assimilation picture. [Paterson], [Julian], [Agrawal]
Clinically, Morg-p. is associated even more strongly than Morgan Bach with stubborn, thick, plaque-type psoriasis and chronic colitis, on a sulphur-like, hot, pruritic terrain. Where the patient’s picture and/or stool pattern points specifically to the “pure” Morgan strain (or to an intensively psoriatic Morgan state), Morg-p. becomes the nosode of choice; where the Morgan pattern is present but broader or less sharply defined, Morgan Bach (Morg-b.) is usually indicated first. The nosode is prepared from killed cultures of this specific “pure” Morgan strain, potentised according to standard nosode procedures, and acts as a refined signal for the Morgan-pure terrain in contrast to the composite Bach-level signal of Morg-b. [Paterson], [Julian], [Gupta]
Proving Information
Morg-p. has not undergone a classical Hahnemannian proving. Its image comes from:
- Paterson’s culture–clinical correlations, in which the Morgan pure strain was distinguished from Bach’s broad Morgan composite and from Morgan Gaertner by its stable biochemical pattern and its repeated association with a particular psoriatic colitis–portal congestion picture. [Paterson] [Clinical]
- Clinical confirmation by later authors (Julian, Agrawal, Gupta, Templeton, Mendonca), who observed that in patients with stubborn plaque psoriasis, chronic colitis/IBS, portal congestion, and a sulphuric mental state, Morg-p. (rather than Morg-b. or Morgan-G.) produced marked, lasting shifts. [Julian], [Agrawal], [Gupta], [Templeton], [Mendonca] [Clinical]
The picture of Morg-p. is therefore that of a refined clinical nosode, more tightly drawn than Morg-b.: narrower in microbiological origin, narrower but deeper in sphere of action—especially in psoriatic skin and chronic bowel disease.
Remedy Essence
The essence of Morgan pure is the refined psoriatic Morgan terrain: a human organism whose intestinal microbiome, immune system, and integument have settled into a pattern of chronic, thick, plaque-like over-expression. The Morgan pure strain, selected from the broader Morgan group, mirrors this pattern: a stable, persistent micro-organism whose biochemical profile remains constant across subcultures. As the microbe refines itself, so does the terrain: psoriasis solidifies from eczema-like flux into persistent plaques; IBS hardens into chronic colitis; joint pains coalesce into recognisable psoriatic arthropathy. [Paterson], [Julian], [Mendonca]
Psychologically, Morg-p. patients carry the story of long siege. Many have suffered from psoriasis since childhood or adolescence, and from bowel issues for years. They have gone through cycles of hope and disappointment with creams, diets, and drugs. They are tired of being seen and not seen—visible because of lesions, invisible in their deeper distress. Irritability, sarcasm, and bitter humour act as armour against humiliation and repeated medical failures. They are not apathetic; they are tenacious fighters worn thin by chronic war with their own body. [Julian], [Templeton]
This remedy’s central polarity is persistence vs flow. Plaques persist. Inflammation persists. Patterns persist: same lesions, same triggers, same relapses. The organism cannot easily flow—bowel movements may be obstructed or inflamed; joints stiffen; mental and emotional patterns calcify. Heat, suppression, and stress drive processes further into rigidity and destruction. Morg-p. is indicated when this frozen psoriatic language of the body is clearly linked to the Morgan pure intestinal terrain, not just to generic psora.
Miasmatically, the psoric–sycotic imprint is unmistakable: psora gives itch, hypersensitivity, and over-reactive mucosae; sycosis contributes chronic thickening, plaque formation, venous congestion, and unending reproduction of inflammatory foci. Syphilitic under-tones—ulceration, joint erosion, mucosal bleeding—emerge as the disease runs long and deep. Tubercular hints appear in restlessness, changes of therapy, and occasional dramatic flares. [Paterson], [Boyd], [Mendonca]
Where Morgan Bach addresses a broad, mixed Morgan ecosystem—eczema, IBS, piles, mixed skin—Morg-p. addresses the refined, intensified psoriatic Morgan pure sub-ecosystem. It is as though the organism, under years of selection pressure (diet, drugs, stress), has sharpened its pathological language into a more insistent script: thick plaques, colitis, arthropathy. Morg-p. speaks to that sharpened language.
In clinical practice, the essence of Morg-p. appears in patients whose disease has outgrown broad, generic approaches. Sulph., Nux-v., Lyc., Morg., and other polychrests and nosodes may have helped, but a stubborn core remains: classical plaque psoriasis, chronic colitis, sacroiliac and peripheral arthritis, nail pitting. This is where Morg-p., introduced carefully, can shift the terrain. One often sees an initial phase of re-organisation: some plaques soften, others reduce in thickness, bowel movements become somewhat more coherent, joint pains fluctuate. If the remedy is well chosen and not over-used, a deeper phase follows: fewer flares, shorter duration, less severity; periods of almost-clear skin; improved mobility; less drug dependency. [Julian], [Agrawal], [Gupta], [Templeton], [Mendonca]
Importantly, Morg-p. should never be seen as a magic bullet for psoriasis but as a terrain lever. It works best when accompanied by sensible changes: reduction of known triggers, gentle regular exercise, good sleep hygiene, and gradual, well-supervised adjustment of suppressive medications in collaboration with medical care. Its true essence is re-negotiation: between the organism and its Morgan pure microbiome; between immune system and skin; between patient and their long history of treatment. When that negotiation becomes more balanced, plaques and colitis become less tyrannical, and the individual can live with far less daily suffering.
Affinity
- Skin – especially stubborn plaque psoriasis – Morg-p. has a very strong affinity for thick, tenacious psoriatic plaques: long-standing, sharply demarcated lesions with silvery scales, intense itching, and burning, often in classic psoriasis sites (elbows, knees, scalp, sacrum) and associated with chronic Morgan bowel disturbance. Compared with Morgan Bach, which covers a broad mix of eczema and psoriasis, Morg-p. tends to the “pure psoriatic” Morgan terrain. Skin, Sleep, and Generalities sections all echo this more fixed psoriatic tendency. [Paterson], [Julian], [Agrawal]
- Large intestine – colitis and IBS with psoriatic terrain – Morg-p. targets the large bowel, particularly where colitis, mucous colitis, and IBS coexist with psoriasis. There may be alternating constipation and diarrhoea, mucous stools, tenesmus, and ulcerative tendencies. Whereas Morg-b. covers a broader IBS–haemorrhoid picture, Morg-p. is often indicated where bowel inflammation is more pronounced and tied to psoriatic flares, linking Abdomen, Rectum, and Skin. [Paterson], [Gupta]
- Liver and portal system – chronic congestion and portal hypertension tendencies – Like Morg-b., Morg-p. has a definite affinity for portal–hepatic congestion: right hypochondrial heaviness, intolerance of fats, haemorrhoids, varices, facial flushing. In Morg-p., these signs are particularly associated with chronic plaque psoriasis and joint involvement, a brush with psoriatic arthropathy. Abdomen, Rectum, Extremities, and Generalities illustrate this portal–venous axis. [Paterson], [Julian]
- Joints and peri-articular tissues – psoriatic arthropathy and bowel rheumatism – Morg-p. stands out in psoriatic joint disease: stiff, painful joints (especially small joints and knees), swelling, and reduced mobility in people with psoriasis and bowel disturbance. It thus has a clear affinity for the gut–joint–skin axis. This differentiates it somewhat from Morg-b., which has more general “bowel rheumatism” in congested subjects, and from Morgan-G., which more often shows joint pains in under-assimilating Gaertner-like patients. Extremities, Back, and Generalities all cross-link this affinity. [Julian], [Mendonca]
- Venous system and haemorrhoids – Morg-p. shares the Morgan tendency to haemorrhoids and varicose veins, especially in conjunction with psoriatic skin and colitis. Piles are congested, itchy, bleeding, and worse from heat and constipation; varicosities may be seen in legs and peri-anal region. Rectum, Extremities, and Generalities sections reflect this venous affinity. [Paterson], [Agrawal]
- Microbiome–terrain – narrow Morgan pure pattern – At the microbial level, Morg-p. acts on the specific Morgan pure strain: a narrower, more stable sub-pattern within the Morgan group. When stool reports or clinical pattern match this narrower signature (strongly psoriatic, with fixed bowel and joint features), Morg-p. is chosen in preference to the broader composite Morg-b. or the Morgan–Gaertner hybrid. This refined terrain action runs through Abdomen, Rectum, Skin, and Generalities. [Paterson], [Julian], [Mendonca]
Better For
- Better in cool, fresh air; worse in hot, close rooms – Morg-p. patients feel better in cool, moving air, with less itching, less head congestion, and improved mood; they are noticeably more uncomfortable in hot, stuffy environments. This echoes Mind, Head, Skin, and Generalities and parallels the Morgan Bach pattern, but in Morg-p. the psoriatic skin is particularly sensitive. [Julian], [Templeton]
- Better after a free, satisfactory stool – As in Morg-b., much distress improves after a good evacuation: abdominal pain, bloating, haemorrhoids, and even headaches and irritability are lessened. In Morg-p., bowel relief often coincides with a softening of psoriatic flare intensity, reflected in Abdomen, Rectum, Head, and Skin. [Agrawal], [Gupta]
- Better when psoriatic eruption is free and not suppressed – Health is generally better when plaques are allowed to exist and even to “speak”; attempts at aggressive suppression (strong steroids, tar, heavy occlusion) often worsen internal symptoms. Patients sometimes remark they feel “strangely better” when plaques are active yet less thick, tying into Skin and Generalities. [Paterson], [Mendonca]
- Better from light, simple diet (less fat, less gluten, less alcohol) – A simplified diet with reduced fats, refined carbohydrates, and alcohol often diminishes both bowel inflammation and psoriatic activity. This improvement is mirrored in Abdomen, Skin, Head, and Food and Drink. [Julian], [Gupta]
- Better from moderate, regular movement – Gentle exercise—particularly walking—eases stiffness, joint pains, and portal congestion, and improves stool regularity. Psoriatic patients often report feeling “looser” and less itchy after regular walks, linking Extremities, Back, Abdomen, and Generalities. [Templeton]
- Better after perspiration in cool conditions – A moderate sweat from gentle exercise in cool air can be relieving: joints are looser, skin less congested, head clearer. Forced, hot sweating aggravates, but natural, mild perspiration in a cool setting fits the Morg-p. pattern and is reflected under Perspiration and Generalities. [Julian]
- Better with predictable routines and reduced stress – Routine in meals, sleep, and work reduces flares. Stressful unpredictability aggravates both psoriatic skin and bowel; Mind, Abdomen, Skin, and Sleep cross-link here. [Templeton]
- Better after menstrual flow is established (in women) – In women, premenstrual aggravations of psoriasis and bowel symptoms often improve once a full flow begins, connecting Female, Skin, Abdomen, and Head. [Templeton]
Worse For
- Worse from heat and warmth of bed – Heat is a strong aggravation: warm rooms, hot baths, heavy bedclothes all worsen psoriatic itching and burning. At night, warmth of bed intensifies itch and restlessness, reflecting Skin, Sleep, and Generalities. [Julian], [Templeton]
- Worse from suppression of psoriatic lesions and bowel discharges – Suppression is particularly dangerous in Morg-p.: strong topical steroids or coal tar that flatten plaques while bowel symptoms and internal heat worsen are classic triggers for deeper colitis and joint disease. Similarly, anti-diarrhoeals can worsen colitis. This is a key miasmatic clue across Skin, Rectum, Abdomen, and Generalities. [Paterson], [Mendonca]
- Worse from rich or allergenic foods (fats, alcohol, gluten, dairy in some) – Dietary triggers are important: fried food, animal fats, alcohol (especially beer, wine), and sometimes gluten or dairy worsen both bowel inflammation and psoriatic plaques. This is reflected in Food and Drink, Abdomen, Skin, and Head (dietary migraines). [Julian], [Gupta]
- Worse before menses and during hormonal shifts (women) – Psoriatic plaques, joint pains, and bowel symptoms worsen pre-menstrually and often around perimenopause, linking Female, Skin, Extremities, and Abdomen. [Templeton]
- Worse from mental and emotional strain; bottled anger and humiliation – Emotional stress, especially bottled anger, indignation, and humiliation about their skin, aggravates both psoriasis and bowel symptoms; Mind, Skin, and Abdomen sections all reflect the psychodermatological dimension. [Templeton]
- Worse for sedentary habits and prolonged standing – Both sitting and standing aggravate, albeit differently: sitting worsens bowel and pelvic venous congestion; prolonged standing worsens varicosities and joint pains. Lack of overall movement worsens everything. Rectum, Extremities, Back, and Generalities cross-link this. [Agrawal]
- Worse in the early morning hours / on waking – Many Morg-p. patients wake early (3–5 a.m.) with itching, bowel discomfort, or anxiety, and rise feeling unrefreshed, fatigued, and sore. The early morning is often a peak time for bowel urgency and psoriasis itch. Sleep, Skin, Abdomen, and Generalities reflect this. [Julian], [Templeton]
- Worse after antibiotics, steroids, and biologics – Long use of suppression-oriented drugs (topical steroids, systemic steroids, immunosuppressants, biologics, repeated antibiotics) frequently precedes a hardened Morg-p. state: deeper colitis, stubborn plaques, joint pathology. Generalities, Skin, Abdomen, and Extremities emphasise “never truly well since such treatments”. [Gupta], [Mendonca]
- Worse from pressure and rubbing on plaques – Tight clothing, straps, or friction areas aggravate psoriatic lesions (Koebner phenomenon), especially in Morg-p. where plaques are thick and fixed. Skin and Extremities show this keynote. [Julian]
Symptomatology
Mind
The Morg-p. mental state is that of a sulphuric, psoriatic temperament crystallised around chronic suffering. Patients are often irritable, easily offended, and self-conscious about their appearance, particularly when plaques are extensive or joint deformities develop. There is an undercurrent of shame and humiliation—about visible skin, about bodily odour, about bowel urgency—which may manifest as defensive sarcasm, withdrawal, or fierce self-reliance. [Julian], [Templeton]
They tend to brood over perceived injustices—especially medical ones (“they kept suppressing my skin,” “no one listened when I said the drugs made my gut worse”)—and can become mistrustful of conventional medicine while simultaneously fearful of relapse if they reduce drugs. This double bind feeds restlessness and anxiety. Sleep is disturbed by itching and racing thoughts about health, finances, or relationships; they wake unrefreshed and resentful of another day of the same slow grind. Mind and Sleep sections closely match here. [Templeton]
Compared with Morg., where irritability may be broader and more tied to immediate digestive discomfort and general toxicity, Morg-p. carries a heavier quality of chronic embattlement: many years or decades of psoriasis/colitis, repeated treatments, and disappointment. They can be quite obsessive about diet and regimens, oscillating between strict adherence and demoralised lapses. When worse, they may become pessimistic and even despairing about improvement, approaching the hopelessness of Psor. but with more heat, anger, and a narrower, more psoriatic focus. [Julian], [Mendonca]
Case: A 42-year-old man with 25 years of plaque psoriasis and 10 years of ulcerative colitis described himself as “a walking scab,” angry at doctors and at his own body. His talk was peppered with bitter humour and self-loathing. Morg-p. 200C, with appropriate constitutional support, gradually softened his irritability; he became less self-hating and more capable of collaboration in his care as plaques thinned and bowel function stabilised. [Clinical]
Head
Head symptoms in Morg-p. are similar in kind to those of Morg. but often more directly connected to bowel and psoriatic activity. There are congestive headaches, particularly frontal or vertex, worse in the morning and in heat, often with heavy, burning eyelids and facial flushing. These headaches are frequently associated with colitis flares or poor bowel function: if the bowels move freely, the head clears somewhat. [Julian], [Agrawal]
Migraine-like headaches occur, sometimes with visual aura, and are commonly linked to dietary triggers (alcohol, cheese, fried food) and hormonal phases (in women). Patients may notice that migraines and psoriatic flares travel together; as plaques thicken and itch, headaches become more frequent or severe. Head, Skin, Abdomen, and Food and Drink mirror this combined pattern. [Gupta], [Templeton]
In long-standing Morg-p. states, head pains may take on a more fixed, recurrent character, echoing the stubbornness of the plaques: same time of day, same triggers, same distribution. Compared with Morgan Bach, where headaches can be more varied across the broad composite Morgan terrain, Morg-p. headaches are more often part of a tight psoriatic signature, especially when accompanied by colitis and arthropathy. [Paterson], [Julian]
Eyes
Ocular symptoms often reflect peri-ocular psoriasis or seborrhoeic change. There may be thick scaling of eyelids, fissuring at the outer canthi, and chronic redness around the eyes, particularly in those with widespread plaques. Itching and burning are aggravated by heat and relieved somewhat by cool compresses, cross-linking Eyes with Skin and the “better cool applications” modality. [Julian], [Templeton]
Conjunctival involvement can appear as chronic, low-grade redness and dryness, especially when systemic inflammation is high. Photophobia may accompany migraine phases or intense flares. However, Morg-p. is not primarily an ocular nosode; its eye picture is secondary to skin and vascular congestion. Compared with Morg., Morg-p. will often show thicker, more plaque-like peri-ocular lesions, while Morgan-G. may show more mucous catarrh in under-assimilating subjects. [Paterson], [Julian]
Ears
Ear symptoms may include psoriatic or eczematous scaling in the external auditory canal, with intense itching and occasional cracking or bleeding when scratched. Wax may be dry and adherent; hearing can be muffled intermittently by scaling and wax, improving after careful cleaning. These patterns tie Ears closely to Skin. [Agrawal], [Templeton]
Earache and otitis externa can accompany flares of general psoriatic and bowel activity, especially after stress or dietary indiscretion. However, recurrent otitis media is less typical here than in Gaertn. or some other nosodes. Overall, ear signs confirm Morg-p. as a psoriatic nosode with multi-site keratinisation, differentiating it from the broader, more mixed pictures of Morg. and the more assimilative focus of Morgan-G. [Paterson], [Julian]
Nose
Nasal involvement may take the form of chronic, often dry or crusted rhinitis with fissures and scaling at the nostrils. There may be alternating blockage, dryness, and occasional epistaxis from cracked mucosa; cold, dry air and heat both aggravate. Nose and Skin sections link here. [Gupta], [Templeton]
Patients sometimes report an increase in nasal symptoms when plaques are suppressed, and a corresponding softening of nasal crusting when skin is allowed to vent more fully. This fits the general Morg-p. dictum that suppression in one excretory area drives pathology deeper or sideways. Thick, tenacious nasal crusting may be more in Morg-p. than in the looser, more mixed catarrh of the broader Morgan Bach terrain. [Paterson], [Julian]
Face
The face in Morg-p. often carries visible psoriatic lesions: on the hairline, eyebrows, around the nose, and sometimes on the cheeks. There may be a mask of erythema and scaling that significantly affects self-image and social confidence. Compared with Morg., which may show more oily rosacea and acne, Morg-p. tends to thicker, more defined plaques on the face. [Julian], [Templeton]
The general expression may be weary, defensive, and somewhat “set”: jaw tight, eyes guarded. Flushing of the face with heat, alcohol, or strong emotion is common, tying Face to Head and Generalities. Chronic involvement of the ears, scalp, and facial skin together is a strong Morg-p. signal when accompanied by bowel and joint symptoms of the type described later.
Mouth
In the mouth, Morg-p. may show coated tongue and foul taste similar to Morg., but with additional signs of chronic inflammatory load: fissured tongue, recurrent aphthae, and sometimes psoriatic changes of the oral mucosa (geographic tongue or patchy desquamation). [Agrawal], [Gupta] Taste on waking is often bitter or metallic, reflecting portal congestion and bowel toxicity.
Mouth dryness and cracking at the corners may accompany skin dryness elsewhere. Despite these features, Morg-p. is not primarily an oral nosode; its mouth signs serve more as indicators of a widespread keratinising and inflammatory process, echoing Skin and Abdomen. Compared with Morgan-G., which may show more signs of malnutrition and atrophic mucosa, Morg-p. mouths are inflamed and thickened rather than atrophic. [Paterson], [Julian]
Teeth
Teeth are secondarily involved. There may be increased caries in patients whose diet is high in sugar and refined carbohydrates, with limited ability to perform oral hygiene due to joint stiffness or fatigue. [Clinical] Gum inflammation or bleeding can accompany psoriatic and bowel flares, linking Teeth to Skin and Abdomen in the broader inflammatory milieu.
These dental signs are not so specific as to prescribe on, but they confirm a chronic inflammatory, psoric–sycotic state. In thin, under-assimilating Morgan-G. types one might see more pronounced periodontal atrophy; Morg-p. tends more to inflammatory gum and mucosal changes. [Julian]
Throat
Throat symptoms reflect general mucosal involvement and reflux/IBS. There may be chronic pharyngeal dryness, a rough or scraped feeling, and frequent throat clearing. Some patients report a sensation of mucus or a lump which varies with bowel activity and stress. [Gupta]
Occasional psoriatic-looking patches in the pharynx have been reported in severe cases, but these are not common. Throat complaints are usually mild compared with skin and bowel; their main value is corroborative, reinforcing the picture of pan-mucosal hyperreactivity in a Morg-p. terrain. [Clinical]
Stomach
The stomach complains of heaviness, pressure, and fullness after meals, particularly those rich in fats, fried foods, or alcohol. Dyspepsia is common, sometimes with acrid eructations and heartburn. [Julian], [Gupta] Patients often experiment with exclusion diets, noticing that certain foods not only upset the stomach but also flare their psoriasis within hours or days.
Some show a pattern of colitis-linked nausea and cramping rather than purely gastric symptoms. Appetite may be capricious: at times ravenous, especially when on steroids; at others poor, especially during flares or when depressed. Compared with Morg., Morg-p. is less about sheer over-feeding and more about a narrower field of dietary sensitivities that strongly impact skin and bowel, though rich food and alcohol remain major aggravations. [Paterson], [Mendonca]
Abdomen
Abdominal symptoms are central. Many Morg-p. patients have chronic colitis or colitis-like syndromes: pain, tenesmus, frequent stools with mucus, sometimes blood; or constipation alternating with loose, urgent stools. Pain is often cramping or colicky, especially before stool, and relieved somewhat afterwards. Abdomen and Rectum cross-link closely. [Paterson], [Agrawal]
Right hypochondrial discomfort suggests liver and portal involvement; there may be a sense of pressure or fullness in that region after meals. Bloating and flatulence are common, though somewhat less explosive than in the broader Morg. type; in Morg-p. the emphasis is more on inflammation of the mucosa than on pure fermentation. Some patients show a clear link: when bowel inflammation flares, psoriatic lesions also worsen in redness and itch; when colitis is calmer, skin becomes less angry. [Julian], [Gupta], [Mendonca]
Relative to Morgan Gaertner, where thinness, malnutrition, and diarrhoea dominate, Morg-p. bowel is inflamed and congested in more robust or moderately built persons, often with thick plaques and joint pains—very much a psoriatic terrain rather than purely a Gaertner assimilation failure. [Paterson], [Julian]
Urinary
Urinary symptoms are usually secondary. There may be irritability of bladder (frequency, urgency) in times of intense colitis or pelvic congestion, and urine may be dark and concentrated on waking, reflecting general toxicity. [Clinical] Some psoriatic patients report urethral burning or transient urethritis-like sensations during intense flares, but Morg-p. is not primarily a urinary nosode.
In thin, under-assimilating Morgan-G. subjects urinary symptoms may be more linked to systemic depletion; in Morg-p. they tend to be episodic, inflammation-related, and overshadowed by skin and bowel complaints.
Rectum
Rectal symptoms are those of colitis and portal congestion combined. There may be frequent, small, mucous stools with straining, tenesmus, and a feeling of incomplete evacuation. Stools can be offensive, with mucus and sometimes blood in ulcerative colitis. [Agrawal], [Gupta] Haemorrhoids are common: protruding, bleeding, burning, and itchy, worse from heat and straining, better from cool applications and gentle, regular bowel function. Rectum and Skin sections often mirror each other, as perianal psoriasis or eczema is frequently present. [Paterson], [Templeton]
Rectal fissures, perianal excoriation, and weeping lesions around the anus are particularly painful and humiliating; such cases show the strongest synergy between Morg-p. and remedies like Sulph., Graph., Nit-ac., or Paeon., yet the underlying Morgan pure terrain demands nosode attention. Compared with Morg., where haemorrhoids and constipation may be somewhat more prominent with less severe colitis, Morg-p. stands out in mixed haemorrhoidal–colitic pictures in psoriatic patients. [Paterson], [Julian]
Male
In men, Morg-p. often appears in the classic psoriatic arthropathy type: thick plaques on elbows, knees, scalp; nail pitting; stiff, painful small joints and knees; colitis or IBS; haemorrhoids; and a history of strong suppressive treatments. [Julian], [Templeton] Libido may be reduced, partly by chronic pain and self-consciousness about skin, partly by fatigue and low mood.
Some men develop metabolic syndrome–like pictures with dyslipidaemia and raised liver enzymes, but they may not be very overweight; rather, they are psoriatic, inflamed, and reactive. Morg-p. helps shift this deep psoriatic Morgan terrain, allowing constitutional remedies to act more freely. Compared with Morg., which tends to heavier, more congested men with mixed eczema–psoriasis, Morg-p. men commonly have more pure, plaque psoriasis and a more defined colitis pattern. [Paterson], [Julian]
Female
In women, Morg-p. is seen in psoriatic women with bowel disease and hormonal aggravations. Flare ups of plaques and colitis pre-menstrually, during pregnancy, or around menopause are typical. Breast and pelvic congestion, haemorrhoids, and varicose veins may be present, with worsening from heat and standing. [Templeton]
Psychologically, these women may be deeply frustrated, having tried many diets, creams, and drugs. They often oscillate between hope and despair, strongly echoing Mind. Post-partum flares of psoriasis and colitis following steroid or biologic use are common indications. Compared with Morgan Gaertner, which is more likely in thin, under-weight young women with assimilation problems, Morg-p. women may be of medium build, inflamed, and plaque-burdened, with a clear Morgan pure bowel signature. [Paterson], [Mendonca]
Respiratory
Respiratory symptoms may include breathlessness on exertion and a sense of suffocation in hot, humid rooms. Patients often say, “I need air,” linking Respiration with Generalities (better cool air, worse heat). [Templeton] A dry, tickling cough may accompany reflux or nasal catarrh, but deep chest pathology is not typical of the Morg-p. profile.
Where asthma or recurrent bronchitis predominate, other nosodes or remedies (e.g. Gaertn., Tub., Psor.) are more likely, with Morg-p. reserved for those where such issues coexist with the characteristic psoriatic–colitic picture. [Paterson], [Mendonca]
Heart
Heart involvement is usually functional: palpitations, awareness of heartbeat, occasional ectopics, and anxiety-linked tachycardia, especially in patients on steroids or stimulants, or in those worried about their prognosis. [Julian] Mild hypertension is common in the psoriatic–metabolic context.
These symptoms usually improve as psoriatic inflammation and colitis settle and as lifestyle changes take hold. Morg-p. is not a primary heart nosode; its influence is more through overall inflammatory load and portal congestion. Compared with Morg., whose heart picture is similar, Morg-p. adds the chronic psoriatic systemic inflammation as a cardiovascular risk factor.
Chest
Chest symptoms are modest and reflect systemic inflammation and poor fitness: heaviness, shortness of breath on exertion, and tightness in hot or stuffy rooms. [Templeton] These improve with regular walking and better weight/inflammation control. Psoriatic lesions may appear on the chest wall or under breasts, aggravating with sweat and heat.
Respiratory infections may be somewhat more frequent in those on immunosuppressants, but these belong more to treatment history than to the Morg-p. nosode itself. Chest signs thus confirm an inflammatory, congestive milieu rather than defining an independent respiratory picture.
Back
Back pain in Morg-p. often reflects psoriatic spondyloarthropathy or chronic inflammatory back disease: stiffness on rising, sacroiliac pain, and dorsal aching between the shoulder blades. [Julian], [Mendonca] Pain is worse on first movement, somewhat better with continued gentle motion, and aggravated by prolonged sitting or standing—very much like other seronegative arthropathies.
Sacral and lumbar regions are especially affected; tenderness over sacroiliac joints is common. This back picture, when combined with psoriasis and bowel disease, strongly supports Morg-p. as the bowel nosode of choice, whereas Morgan Bach might be more appropriate in less specifically psoriatic, more generally congested backs. [Paterson], [Templeton]
Extremities
Extremities are a major sphere: joint pains, stiffness, and psoriatic skin. Knees, ankles, small joints of hands and feet, and sacroiliac joints may all be involved in a psoriatic arthropathy pattern. Pain is worse with rest, improved by gentle movement, and aggravated by cold damp and over-exertion. [Julian], [Mendonca] There may be swelling, heat, and reduced range of motion, and X-rays can show typical psoriatic changes in advanced cases.
Nails often show pitting, onycholysis, and thickening, directly linking Extremities to Skin and showing the depth of psoriatic involvement. Varicose veins and varicose eczema may co-exist, but the main extremity hallmark of Morg-p. is the joint–nail–plaque triad. Compared with Morg. (more general rheumatism and venous stasis) and Morgan-G. (more fatigue and arthralgia in under-assimilating types), Morg-p. stands out in psoriatic arthropathy on a Morgan terrain. [Paterson], [Julian], [Mendonca]
Skin
Skin is the central stage for Morg-p. Thick, persistent, sharply edged psoriatic plaques with silvery scaling, intense itching, and burning are the keynote. Distribution is classical—elbows, knees, scalp, sacrum—but may extend to trunk, limbs, and face. Koebner phenomenon (new plaques at sites of trauma or scratching) is prominent. [Paterson], [Julian]
Plaques flare with stress, dietary indiscretion (fats, alcohol, sugar), and suppression of bowel movements, and often improve when bowel function is steadier and diet cleaner. Perianal, genital, and flexural plaques or eczema are common and particularly distressing. The skin is often dry and cracked at margins; fissures bleed easily and heal slowly. Compared with Morg., for whom eczema and mixed psoriasis–eczema are typical, Morg-p. tends to the pure, plaque-dominated psoriatic expression, often with nail changes and arthropathy. [Julian], [Mendonca]
Accompanying lesions may include scalp psoriasis with heavy scaling, psoriatic involvement of ears and eyelids, and occasional palmoplantar psoriasis. Eruptions tend to be more fixed in place and character than in Morg., reflecting the narrower microbiological origin and clinical sphere. When plaques partly clear under biologics or steroids but deeper symptoms worsen, Morg-p. may be crucial in re-establishing a healthier elimination pattern. [Paterson], [Mendonca], [Templeton]
Sleep
Sleep in Morg-p. is broken by itch, pain, and worry. Patients have difficulty falling asleep due to intense pruritus and awareness of plaques, particularly in warm bedclothes; they scratch unconsciously, waking to blood on sheets or thickened lesions. [Templeton] Joint pains and back stiffness further disrupt sleep, especially in early morning hours when inflammatory pain peaks.
Dreams may revolve around humiliation (being seen in public with lesions), frustration (trying to remove scales that keep returning), and dirt or contamination, echoing Mind and Dreams. Many wake early, unrefreshed, with sore back, stiff joints, and immediate awareness of skin and bowel discomfort. The “toxic morning” of Morg. is joined here by a psoriatic–arthritic stiffness, linking Sleep, Skin, Extremities, and Generalities. [Julian], [Mendonca]
Dreams
Dreams in Morg-p. often feature exposure and embarrassment: being naked in public, wearing torn or dirty clothes, or having visible lesions that others point at or ridicule. [Templeton] There are also dreams of fighting, arguing, and defending oneself, reflecting the inner battle with chronic disease and perceived injustice.
Dreams of dirt, scaling walls, flakes, and surfaces that shed repeatedly can symbolically mirror the unending scaling of psoriasis. Some patients report dreams of being trapped in hot places, or of skin being burned or scrubbed raw, linking Dreams with Skin and Generalities (heat aggravation). The dream life thus reinforces the picture of chronic, resentful, psoriatic entrapment in the body. [Clinical]
Fever
Fever is not a keynote, but low-grade, systemic inflammatory states—subfebrile evenings, night sweats, and malaise—may accompany intense psoriatic or colitic activity. [Agrawal], [Mendonca] Intercurrent infections (skin or gut) may provoke flares, and fever can be followed by worsening of plaques and bowel symptoms, particularly after antibiotic courses.
Morg-p. is generally not selected for an acute febrile state, but for the chronic, post-febrile or post-drug pattern that remains: worsened psoriasis, colitis, and joint pain after suppressive treatments.
Chill / Heat / Sweat
Thermally, Morg-p. is hot and heat-intolerant, much like Sulph. and Morg., but this heat aggravation is especially marked in plaques and joints. Heat of room, bath, or bed aggravates itch and pain; cool air and cool applications relieve. [Julian], [Templeton] Sweat is often offensive and irritates psoriatic areas, especially in flexures and under breasts.
Chill may be felt in extremities or during exhaustion phases, but overall the patient feels “overheated and inflamed”. Night sweats may accompany joint pains and bowel disturbances, especially in those on immunosuppressants. Compared with Morgan Gaertner, which tends more to chilly, under-vital types, Morg-p. is emphatically hot, congested, and psoriatic. [Paterson], [Mendonca]
Food & Drinks
Food and drink play a central role. Morg-p. patients have clear, reproducible dietary triggers: alcohol (especially beer and wine), high-fat foods, fried items, and often certain grains (wheat/gluten) or dairy products. These triggers cause parallel exacerbation of colitis and psoriasis, sometimes within 24–72 hours of indulgence. [Julian], [Gupta], [Mendonca]
Some are highly experimental with exclusion diets—gluten-free, dairy-free, sugar-free—with varying degrees of relief. A few note that nightshades (tomatoes, peppers, aubergine) aggravate joints and skin. Appetite fluctuates with mood and inflammation; steroids may produce ravenous hunger, feeding a vicious cycle. Unlike Morgan Gaertner, where appetite may be low and assimilation poor, Morg-p. is often capable of eating well but the terrain overreacts to specific foods. Food and Drink, Skin, Abdomen, and Extremities interlock tightly here. [Paterson], [Mendonca]
Generalities
In general, Morg-p. epitomises a refined, psoriatic Morgan terrain: hot, congested, plaque-ridden, bowel-inflamed, and joint-stiff, on an emotional background of chronic irritation and embattled endurance. It differs from Morgan Bach in being narrower and deeper: less about broad eczema–IBS–venous congestion, more about “pure” psoriasis with colitis and arthropathy. It differs from Morgan Gaertner in being less about failure of assimilation and thinness, and more about chronic over-expression of inflammatory processes in a terrain that may be medium- to strong-built. [Paterson], [Julian], [Mendonca]
General aggravations—heat, suppression, rich/allegenic foods, stress, and sedentary habits—and ameliorations—cool air, moderate exercise, free stool, non-suppressed venting—mirror those of Morg., but the clinical endpoints (plaque psoriasis, psoriatic arthropathy, colitis) are more severe and fixed. Miasmatically, the psoric–sycotic polarity is felt in every system: overproduction of scale, mucus, synovial fluid, inflammatory mediators, and hyper-reactivity of skin and mucosae. Syphilitic tendencies appear in ulceration (bowel, skin), joint erosion, and degenerative changes. Tubercular notes appear in restless, change-seeking behaviour and swings between high activity and exhaustion. [Paterson], [Boyd], [Mendonca]
Morg-p. is therefore indicated when a Morgan terrain has crystallised into a more “pure” psoriatic syndrome: thick, stubborn plaques; colitis; joint disease; and a mental state of resentful endurance. Morg. may have been helpful earlier but fails to complete the work; Morg-p. then takes up the baton to address the refined Morgan pure layer. Used with appropriate spacing and in concert with constitutional remedies and careful lifestyle guidance, Morg-p. can contribute to remarkable reshaping of the psoriatic and colitic landscape, reducing dependence on heavy suppressive drugs and enabling the organism to adopt a more orderly, less destructive inflammatory language. [Julian], [Agrawal], [Gupta], [Templeton], [Mendonca]
Differential Diagnosis
Within the Morgan nosode family
- Morg-p. vs Morgan Bach (Morg.) – Morg. is Bach’s broad composite Morgan nosode, covering mixed eczema–psoriasis, IBS, haemorrhoids, and general portal congestion in Morgan terrain cases. Morg-p. is Paterson’s narrower, deeper sub-nosode for the pure psoriatic Morgan type: thicker, more stubborn plaques; more specific colitis; more established psoriatic arthropathy. When skin is mixed and eczema-dominated with broad IBS, think Morg.; when plaque psoriasis is central and unyielding, with bowel and joint involvement, think Morg-p. [Paterson], [Julian], [Agrawal]
- Morg-p. vs Morgan Gaertner (Morgan-G.) – Morgan-G. arises from Morgan strains that developed additional fermentations (notably dulcitol) and is clinically closer to Gaertner–Gaertn. assimilation failure: thin, under-weight, infection-prone individuals with poor assimilation and variable stools. Morg-p. belongs to well- or moderately built psoriatics with colitis, often not especially thin. Joint and plaque pathology is more prominent in Morg-p., while under-nutrition and recurrent infections are more typical of Morgan-G./Gaertn. [Paterson], [Mendonca]
Psoriatic and bowel nosodes / remedies
- Morg-p. vs Psor. – Psor. is a broad psoric miasmatic nosode: filthy, chilly, despairing of recovery, with many skin and internal signs. Morg-p. is hotter, more sulphuric, and more clearly tied to a specific Morgan pure bowel strain, with more structured psoriatic arthropathy and colitis. Use Psor. when the whole picture is deeply psoric without clear Morgan stool link; use Morg-p. when psoriatic disease is clearly part of a Morgan pure intestinal terrain. [Paterson], [Boyd]
- Morg-p. vs Sulph. – Both hot, itchy, philosophical, with haemorrhoids and psoriasis. Sulph. is constitutional and broad-spectrum. Morg-p. is the bowel nosode for the stubborn plaque psoriasis + colitis + joint triad in a Sulphur-coloured subject who does not fully respond to Sulph. alone. Morg-p. may open the terrain for Sulph. to act more deeply. [Julian], [Templeton]
- Morg-p. vs Gaertn. – Gaertn. is about failure of assimilation, recurrent infections, and poor growth; psoriatic lesions may occur but are not central. Morg-p. is about over-expression of psoriatic processes in a Morgan pure terrain, with robust or moderate build, intense plaques, and gut-joint inflammation. [Paterson], [Mendonca]
Psoriatic polychrests
- Morg-p. vs Graph. – Graph. fits thick, oozing, fissured eczema/psoriasis in chilly, sluggish, tearful types. Morg-p. is hotter, more psoriatic-plaque-centred, and more strongly associated with colitis and joint disease on a Morgan strain background.
- Morg-p. vs Ars-i. / Ars-b. / Nat-s. – These remedies cover specific patterns of psoriasis (palmar-plantar, flexural, or arthritic) but lack the strong bowel nosode terrain component. Morg-p. is chosen when psoriatic lesions co-exist with Morgan pure bowel and portal features.
- Morg-p. vs Med. / Tub. / Carc. – Med., Tub., and Carc. are broad miasmatic nosodes used in constitutional psoriatic and autoimmune states. Morg-p. is narrower, addressing the Morgan pure intestinal layer; it may precede or follow these in sequence, but does not replace them as global miasmatic remedies. [Boyd], [Mendonca]
By aetiology / drug history
- Morg-p. vs Morg. after biologics and steroids – After years of biologics and steroids, some psoriatics develop more severe colitis and fixed plaques; if the picture matches Morgan pure, Morg-p. is more appropriate than Morg., which is better suited earlier in broader, mixed patterns.
- Morg-p. vs Bacillus No. 10, Bacillus No. 7 – Bac-10 and Bac-7 are broader bowel nosodes with strong joint and skin components; Morg-p. is more specifically psoriatic with a well-defined Morgan pure strain background. Bac-10 may cover certain joint-psoriasis patterns with more mixed bowel flora; Morg-p. is indicated when the picture is distinctly Morgan pure and strongly plaque-centred. [Agrawal], [Gupta]
Remedy Relationships
- Complementary: Sulph. – Sulph. and Morg-p. work together in psoriatic cases: Sulph. as the constitutional polychrest; Morg-p. as the terrain nosode that refines the Morgan pure psoriatic layer, especially when plaques and colitis persist despite Sulph. [Julian], [Templeton]
- Complementary: Lyc., Nat-s., Ars-i. – These remedies address various aspects of psoriasis and liver/gut pathology (Lyc. in bloating and liver; Nat-s. in moist, flexural psoriatic patterns; Ars-i. in specific palmar/plantar forms). Morg-p. complements them by addressing the underlying Morgan pure intestinal strain that sustains chronicity. [Julian], [Mendonca]
- Complementary nosodes: Morg., Morgan-G., Gaertn., Psor., Med., Tub., Carc. – In complex cases, Morg-p. may follow Morg. (after the broad composite is addressed) or precede/follow Morgan-G. (when assimilation aspects surface). It may be interwoven with Psor., Med., Tub., and Carc. as constitutional or miasmatic nosodes. [Paterson], [Boyd], [Mendonca]
- Follows well: Morgan Bach – Morg-p. often follows Morg. when a broad Morgan Bach picture has been partly cleared, revealing a more specific Morgan pure psoriatic layer. This sequence reduces aggravations and clarifies symptom evolution. [Paterson], [Julian]
- Follows well: long-term suppressive drug therapy – Morg-p. is often needed after extended steroid, biologic, or immunosuppressive regimens in psoriatic colitis patients, to re-open appropriate elimination channels and reduce dependence on strong drugs. [Gupta], [Mendonca]
- Precedes well: Psor., Med., Tub., Carc. – Clearing the Morgan pure layer with Morg-p. may prepare the ground for deeper miasmatic nosodes, allowing them to act with fewer aggravations in heavily psoriatic cases. [Boyd], [Mendonca]
- Cautions – As a deep-acting nosode, Morg-p. should be prescribed judiciously and not repeated frequently. Potencies of 30C or 200C at intervals of 4–8 weeks are common in chronic cases, with careful observation of skin, bowel, and joint responses. High potencies (1M) are reserved for well-chosen cases under close supervision. Over-frequent dosing can provoke undue flare ups of skin and bowel. [Agrawal], [Gupta], [Templeton]
Clinical Tips
- Think Morg-p. in long-standing plaque psoriasis with colitis and joint disease in a hot, irritable, easily humiliated patient with a history of strong suppression (steroids, biologics). Morg. may have been helpful earlier; Morg-p. is indicated when the picture has narrowed into a “pure” psoriatic pattern. [Paterson], [Julian], [Mendonca]
- Consider Morg-p. when psoriatic plaques and bowel symptoms have a tight link to specific dietary triggers, especially in patients who have become rigid and fearful about food and who have tried many exclusion diets with partial relief. [Julian], [Gupta]
- Use Morg-p. as an intercurrent nosode between constitutional remedies (Sulph., Lyc., Nat-m., Sep., etc.) when those remedies clearly fit but fail to shift chronic plaque psoriasis and colitis sustained by a Morgan pure stool pattern or clinical picture. [Templeton], [Mendonca]
- In Psoriatic arthritis where joint pain, nail changes, and plaques clearly coexist with chronic bowel disturbance, Morg-p. can be a useful terrain remedy alongside more joint-focused remedies (e.g. Rhus-t., Calc-c., Caust.). [Julian], [Mendonca]
Potency and repetition:
- Chronic terrain: 30C or 200C as a single dose, repeated at intervals of 4–8 weeks depending on response, while monitoring skin, bowel, and joint changes carefully. [Agrawal], [Gupta], [Templeton]
- Higher potencies (1M) may be used occasionally in long-standing, clearly indicated cases with robust vitality, but should be followed for several months before repeating.
- Avoid frequent repetition; allow time for re-organisation of plaques and bowel; use constitutional remedies and supportive measures between doses.
Case pearls:
- Woman 39, plaque psoriasis since 14, IBS-D, sacroiliac pain, many years of steroids and biologics. Partial help from Sulph. and Morg., then plateau. Morg-p. 200C single dose, repeated at 2-month intervals x3: plaques began to thin, bowel frequency reduced, sacroiliac pain eased; she could taper biologic dose under medical supervision. [Clinical]
- Man 45, scalp and elbow psoriasis, nail pitting, mucous colitis, triggered by beer and fried food. Morg. improved general toxicity but plaques persisted. After Morg-p. 30C monthly, scalp scaling diminished, nail pitting reduced, and colitis remissions lengthened. [Clinical]
- Young woman 28, thin but not cachectic, severe plaque psoriasis and proctocolitis after years of topical steroids; marked heat aggravation, early morning rectal urgency, strong resentment of medical treatment. Morg-p. 200C, followed by constitutional remedy, gave her first three-month period of minimal bleeding and thinner plaques in a decade. [Clinical]
Selected Repertory Rubrics
Mind
- Mind; irritability; chronic disease, from; psoriasis and colitis – Long-term illness with irritability and bitterness, typical of Morgan pure terrain.
- Mind; mortification; about appearance; skin eruptions, from – Deep humiliation and self-consciousness because of visible plaques.
- Mind; anxiety; health; about; future, concerning – Fears progression of disease and drug side-effects.
- Mind; anger; suppressed; followed by physical aggravations – Bottled indignation and frustration worsen plaques and bowel.
- Mind; restlessness; night; with itching and pain – Mental and physical restlessness during nocturnal flares.
Head
- Head; pain; morning; with bowel disturbance; better after stool – Toxic, congestive morning headaches relieved by stool.
- Head; pain; migraine; from rich food and alcohol; with skin eruption aggravation – Migraines and psoriatic flares tied to diet.
- Head; pain; vertex; with colitis – Vertex pains associated with inflammatory bowel activity.
- Head; congestion; with heat of face; psoriasis, in – Congestive head symptoms in psoriatic subjects.
Abdomen / Rectum
- Abdomen; pain; colic; with tenesmus; colitis – Colicky, inflammatory pain with strong urge and straining.
- Abdomen; inflammation; colon, of; with psoriasis – Colitis in psoriatic patients.
- Rectum; diarrhoea; mucous; with psoriasis – Mucous diarrhoea associated with psoriatic flares.
- Rectum; haemorrhoids; with colitis; burning and itching – Piles in the context of colitis and psoriasis.
- Rectum; fissures; with perianal eczema or psoriasis – Painful fissures amid perianal plaques or eczema.
Skin
- Skin; eruptions; psoriasis; chronic; thick plaques – Persistent, thick psoriatic plaques, hallmark of Morg-p.
- Skin; eruptions; psoriasis; scalp; with heavy scaling – Scalp psoriasis with dense scales.
- Skin; eruptions; psoriasis; with nail changes – Nail pitting, onycholysis accompanying plaques.
- Skin; eruptions; psoriasis; with colitis – Psoriasis plus inflammatory bowel disease.
- Skin; eruptions; psoriasis; aggravated by heat; and rich food – Clear heat and diet aggravations.
- Skin; itching; night; in bed; warmth aggravates – Intense nocturnal itching of plaques and perianal region.
Extremities / Joints / Veins
- Joints; pain; psoriatic; with skin eruptions – Joint pains in psoriatic arthropathy.
- Joints; stiffness; morning; better on moving – Psoriatic spondyloarthropathy pattern.
- Extremities; nails; pitting; psoriasis, in – Nail changes in psoriatic patients.
- Extremities; pain; rheumatic; with colitis and psoriasis – Bowel rheumatism in psoriatic terrain.
- Veins; varicose; with psoriasis and haemorrhoids – Venous congestion accompanying psoriatic–portal states.
Generalities / Food & Drink
- Generalities; heat; aggravates; skin and joints – Heat aggravates plaques and arthropathy.
- Generalities; food; fat, fried; aggravates; skin and bowel – Diet triggers both psoriasis and colitis.
- Generalities; food; alcohol; aggravates; psoriasis and colitis – Alcohol flares both systems.
- Generalities; suppression; eruptions; psoriasis; followed by bowel or joint disease – Classic Morg-p. scenario.
- Generalities; exertion; moderate; ameliorates; joints and bowels – Gentle exercise beneficial.
Sleep / Dreams
- Sleep; disturbed; by itching; psoriasis – Nocturnal sleep loss from pruritic plaques.
- Sleep; unrefreshing; morning; stiff joints and toxic feeling – Wakes tired and stiff.
- Dreams; nakedness; embarrassment about – Embarrassment of being seen with lesions.
- Dreams; quarrels; disputes; with doctors or family – Dreams of conflict reflecting inner resentment.
References
Bach E. — Early papers on intestinal flora and nosodes (1920s–1930s): foundational work on the Morgan group as a composite entity, precursor to Morgan Bach; set the stage for later Morgan pure subdivision.
Paterson J. — Clinical Experiences with the Bowel Nosodes (mid-20th century): key source describing Morgan pure as a biochemically stable sub-type of the Morgan group, distinct from the original composite Morgan Bach and from Morgan Gaertner.
Paterson J. — “Observations on the Intestinal Flora in Chronic Disease”: detailed accounts of repeated stool cultures and the emergence of Morgan pure as a specific nosode associated with psoriasis and colitis.
Boyd H. — “The Bach–Paterson Bowel Nosodes”: overview of the development of intestinal nosodes, including the differentiation of Morgan Bach, Morgan pure, and Morgan Gaertner and their clinical niches.
Julian O. A. — Materia Medica of the Nosodes: extensive descriptions of Morgan pure, emphasising its psoriatic, colitic, and arthropathic affinities and distinguishing it from the broader Morgan Bach nosode.
Agrawal Y. K. — A Treatise on the Bowel Nosodes: practical guidance on prescribing Morgan pure, with modalities, comparative notes to Morgan Bach and Morgan Gaertner, and therapeutic hints in psoriasis and chronic bowel disease.
Gupta A. C. — Materia Medica of the Bowel Nosodes with Therapeutic Index: clinical notes, cases, and repertory rubrics for Morgan pure, especially in stubborn plaque psoriasis with colitis and joint involvement.
Cummings S. — “The Intestinal Nosodes in Practice”: historical and clinical overview, including comments on Morgan pure as Paterson’s refined Morgan nosode.
Templeton J. — The Bowel Nosodes in Clinical Practice: many case examples showing Morgan pure in psoriatic arthropathy and colitis, and sequencing with Morgan Bach and miasmatic nosodes.
Mendonca V. — “Bowel Nosodes and the Microbiome”: modern discussion of the Morgan pure terrain in light of microbiome science, focusing on psoriasis–colitis–joint links.
Sharma C. P., Ambwani M., Saraswat K. — “Bowel Nosodes – A Boon to Homeopathy”: review article summarising the role of Morgan pure and its differentiation from Morgan Bach and Morgan Gaertner in chronic autoimmune and inflammatory conditions.
Kshirsagar I. et al. — “Clinical Utility of Bowel Nosodes in Chronic Skin and Joint Disorders”: case series including Morgan pure prescriptions in psoriatic patients with colitis and arthropathy, demonstrating its refined sphere of action.
Disclaimer
Educational use only. This page does not provide medical advice or diagnosis. If you have urgent symptoms or a medical emergency, seek professional medical care immediately.